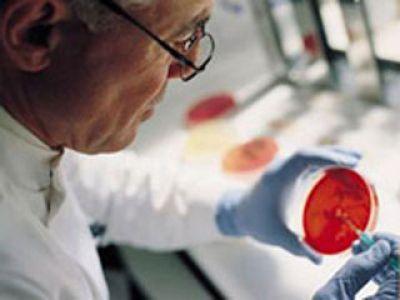
Использование стволовых клеток

Вы здесь
Сейчас стволовые клетки (чаще всего эмбриональные) пытаются использовать для восстановления работы самых разных органов. Также из них уже создаются, в прямом смысле - выращиваются, некоторые органы. В частности, уже несколько лет выращиваются мочевые пузыри и зубы, и эту технологию кое-где начали применять в лечебной практике.
Что лечат с использованием стволовых клеток
Совсем недавно британские ученые разработали уникальный метод лечения слепоты с помощью эмбриональных клеток. Этот способ направлен на ликвидацию самой распространенной причины слепоты - возрастной дегенерации макулы (центральной части сетчатки). Ведутся также исследования с целью улучшения работы сердца путем введения стволовых клеток в коронарную артерию. С их же помощью лечат - пока только в лабораториях - тяжелый цирроз печени и выращивают суставы. Уже более пяти лет назад в одном из ведущих центров нашей страны был выращен новый сустав для израильской девочки, которая родилась без него. Ее лечили полгода, сустав был выращен, и теперь она может свободно ходить.
Кроме этого, стволовые клетки дают надежду на реальную помощь в борьбе с таким коварным заболеванием, как туберкулез. В ведущих профильных НИИ России уже проводятся опыты (пока на животных). Возможно, в скором времени будут обнародованы результаты исследований. На очереди «пришествие» стволовых клеток в область лечения таких заболеваний, как болезни Паркинсона и Альцгеймера: существует обнадеживающее предположение, что они позволят значительно сдерживать и даже обращать вспять вызванные этими недугами разрушительные изменения в организме. Не вызывает сомнений, что стволовые клетки также найдут научное применение в области тестирования лекарств и других биологических препаратов.
Если вы ищете где заказать шкафы лабораторные, рекомендуем обратить внимание на каталог торгового дома "Аверс". Здесь вы найдете качественную медицинскую и лабораторную мебель Российских производителей.
Поиск новых источников
Еще одним быстро развивающимся направлением исследований в этой сфере является поиск новых источников стволовых клеток, этому ученых побудило понимание того, что невостребованные после ЭКО эмбрионы не являются единственным возможным их «рассадником». Напряженная работа уже дает результаты. Вероятно, в будущем, чтобы «залатать» поврежденную кость или восстановить сустав, врачу будет необходимо только сделать простой укол в руку пациента.
Технология забора и обработки стволовых клеток при массовом применении вполне может стать недорогой и доступной для любого человека.
Сейчас трудно сказать, когда технологии лечения стволовыми клетками станут широко применяться в медицинской практике. Еще труднее сказать, когда они станут доступными по цене для большей части населения. Но рано или поздно это произойдет. Надо только постараться прожить лет 15 лет без тяжелых заболеваний, а к тому времени медицина научится их лечить с помощью стволовых клеток!
